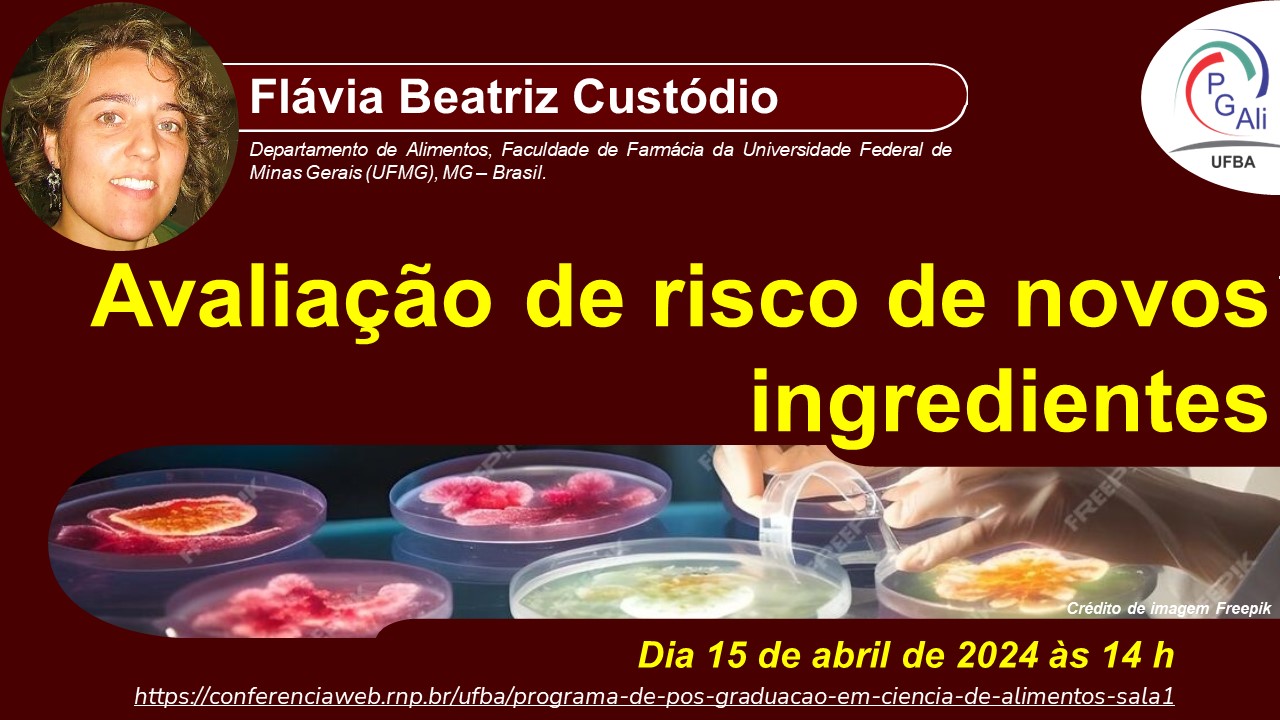

Assista no canal do PGAli: https://conferenciaweb.rnp.br/ufba/programa-de-pos-graduacao-em-ciencia-de-alimentos-sala1
Português, Brasil
Imagem:


Assista no canal do PGAli: https://conferenciaweb.rnp.br/ufba/programa-de-pos-graduacao-em-ciencia-de-alimentos-sala1